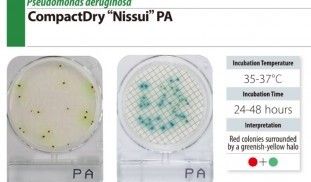
Compact Dry PA Compact Dry PA show.jpg
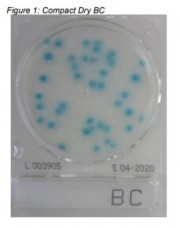
compact dry BC compact dry BC EXP 04_2021.jpg
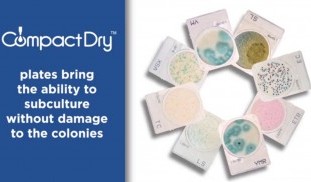
Compact Dry Microbial Count Compact Dry info show.jpg

ตลับเพลทอาหารเลี้ยงเชื้อ พร้อมใช้สำเร็จรูป compact dry plates
Compact Dry เป็นตลับเพลทฉาบอาหารเลี้ยงเชื้อจุลินทรีย์ต่างๆ แบบแห้ง ชนิดสำเร็จรูปพร้อมใช้งาน สะดวกใช้ได้ง่าย
สามารถ อ่านผลได้ชัดเจน เหมาะสำหรับการตรวจตัวอย่าง จากอาหารชนิดต่างๆ น้ำ อาหารเลี้ยงสัตว์ ฯ
เพื่อนับจำนวนปริมาณรวมทั้งหมดของแบคทีเรีย หรือ จุลชีพก่อโรคต่างๆ รวมถึง ยีสต์และเชื้อรา (determination and quantification of aerobic mesophilic count)
- ผลิตภัณฑ์ของ Nissue Pharma. (ISO 9000/13845 ) ได้รับการรับรองสากลจาก AOAC/ Microval / NordVal
- ไม่ต้องยุ่งยากกับในการเตรียมและควบคุมคุณภาพมีเดียร์ แบบวุ้นดั่งเดิม
- ขนาดบรรจุกล่องละ10ซองฟรอยด์ ซองละ4ตลับเพลท ( 40 / 100 / 240 plate covers)
- เก็บไว้ใช้ได้นาน ถึง12-18เดือน ที่อุณหภูมิห้อง 30°C
- ตัวอย่างสารทดสอบสามารถแพร่ไปบนเพลทได้อย่างสม่ำเสมอ
- มีแผ่น cover ปิดป้องกันอันตราย จากการฟุ้งกระจาย
- ขนาดพอเหมาะ พื้นที่ Growth area =20 cm2 ขนาด Ø 47 mm. สามารถนำมาซ้อนกันได้ นำใช้ที่จุดทดสอบได้ง่าย
- โคโลนีเต็บโตได้ทั้ง3มิติ จึงเก็บตัวอย่างโคโลนีเพื่อทดสอบเพาะเชื้อยืนยันผลได้ง่าย
- อ่านผลง่าย เห็นสีได้ชัดเจน
- มีเอกสาร MSDS และ Certification of Analysis ( CoA )เมื่อส่งมอบสินค้า
- ISO 9001 certified, ISO 16140 Validated*
- ผลิตได้ตามคุณภาพ ISO 9001:2015 และ ISO 13845 และการทดสอบผ่านการรับรองของ AOAC approval / MicroVal certification / NordVal certification ** มีเอกสาร MSDS และ CoA

ตลับเพลทอาหารเลี้ยงเชื้อจุลินทีย์ แบบสำเร็จรูป สำหรับห้องปฏิบัติการจุลชีววิทยา
ช่วยให้การเพาะเลี้ยงเชื้อ ง่าย ไม่ยุ่งยาก อ่านผลชัดเจน มีฝาครอบ ปลอดภัย
เพื่อตรวจความปลอดภัยในการบริโภค ตามเกณฑ์ข้อกำหนดมาตรฐานทางจุลชีววิทยา
- จำนวนจุลินทรีย์ทั้งหมด (Total Count )* AOAC No. 010404
- จำนวนเชื้อยีสต์และรา (Yeast & Mold) AOAC-RI No. 100401
- จำนวนเชื้อยีสต์และราแบบรวดเร็ว (YMR) ISO 16140-2:2016
- จำนวนเชื้ออีโคไลและโคลิฟอร์ม ( E.coli and Coliforms) AOAC-RI No. 110402
- จำนวนเชื้อโคลิฟอร์ม (Coliform)
- เชื้อสตาฟิโลค๊อกคัส ออเรียส (Staphylococcus aureus) AOAC-RI No. 81001
- เชื้อซาลโมเนลลา (Salmonella)จากเพลทอาหารคัดเลือก*
- เชื้อวิบริโอ พาราเฮโมไลติคัส (Vibrio parahaemolyticus)
- เชื้อบาซิลลัส ซีเรียส (Bacillus Cereus) MicroVal 2011LR41
- เชื้อลิสทีเรีย โมโนไซโตจีเนส ISO 11290
- เชื้อซูโดโมแนส แอรูจิโนซา MicroVal 2017LR66
- ผลิตได้ตามคุณภาพ ISO 9001:2015 และ ISO 13845 และการทดสอบผ่านการรับรองของ AOAC approval / MicroVal certification / NordVal certification

Options
- Compact Dry Swab : Environmental sampling swabs สวอบสำหรับเก็บตัวอย่างจุลินทรีย์ จากบนพื้นผิวสัมผัสอาหาร เช่น ผิวโต๊ะประกอบอาหาร เช็ดพื้นที่ 5x10 ตร.ซม. (50 ตารางเซนติเมตร)
- Dilution Rack แบบต่างๆ สำหรับเจือจางทดสอบ หรือ ตรวจสอบด้วยตลับเพลทหลายๆ ชนิด
- small incubator,
- incubox (thermocult),
- whirl-pak bags,
- disposables,
- steriware,
- sterilizing solution ( disinfactants ), etc.
สินค้าใกล้เคียง:
- Contact slide หรือ Contact Plate แผ่นสไลด์ต่างๆ มี20 ชนิดอาหารเลี้ยงเชื้อ* ใช้กดหรือจุ่ม สำหรับตรวจหาปริมาณจำนวนแบคทีเรีย และเชื้อก่อโรคต่างๆ จากบนพื้นผิวสะอาด มือ ภาชนะใส่อาหาร หรือ ของเหว เพื่อตรวจประเมินสภาพสุขอนามัย hygiene monitoring tests , dip-slide culture tests
- Rodac Plates จานเพลทสัมผัสเชื้อ Replication Organism Detection and Counting โดยมีอาหารเลี้ยงเชื้อต่างๆ ที่นูนออกมาเหนือจานเพาะเชื้อ (peel plate) เพื่อการเก็บตัวอย่างเชื้อจุลินทรีย์ต่างๆ แบบวางกด stamp จากพื้นผิวสัมผัส สำหรับการทดสอบ hygeine surface test

-
ตลับเพลทตรวจนับจุลินทรีย์รวมทั้งหมด (Total Plate Count) Bacteria โคโลนี เป็นจุดสีแดง Compact Dry TC เป็นอาหารเลี้ยงเชื้อแบคทีเรียรวมทั้งหมด Total Count พร้อมใช้ ใน แบบ Dry...
-
เชื้อจุลินทรีย์ที่ปนเปื้อนในเครื่องสําอาง อาจเป็นเชื้อก่อโรค หรือ เชื้อฉวยโอกาส รวมทั้งเชื้อไม่ก่อโรค ตลับเพลทตรวจนับเชื้อ PA ใช้สำหรับตรวจเชื้อจุลินทรีย์ที่ก่อให้เกิดโรค ชนิดซูโด...
-
Compact dry YM ตลับเพลทตรวจนับเชื้อยีสต์และรา YM Yeast ยีสต์มีโคโลนีมันวาว Mold เชื้อรามีโคโลนีสีฟ้าเขียว การรับรอง MicroVal (certificate No. RQA2008LR10) NordVal (certificate No...
-
ตลับตรวจนับเชื้อ Staphylococcus aureus (X-SA) เชื้อสตาฟิโลค๊อกคัส ออเรียส Staphylococcus aureusColonies : Light Blue/Blue Inc. 24 h incubation time at 37 °C การรับรอง MicroVal (...
-
การรับรอง MicroVal (certificate No. MV0806-004LR) NordVal (certificate No.036) AOAC-RI (certificate No. 110402) Compact Dry ECตลับเพลทตรวจนับจำนวนเชื้อ E.Coli และ เชื้อColiform...
-
ตลับเพลทตรวจนับเชื้อ บาซิลลัส ซีเรียส Bacillus Cereus Compact dry BC เป็นตลับเพลท ที่ฉาบอาหารเลี้ยงเชื้อจุลินทรีย์ต่างๆ แบบแห้ง ชนิดสำเร็จรูปพร้อมใช้ Ready To Useสำหรับงานทางด้านจ...
-
Compact Dry LSตลับตรวจเชื้อลิสทีเรียListeria spp. สี Colonies : Light Blue/Blue ฟ้า การอุ่นสาร Inc. ( Qualitative ) 24 +/- 2 h incubation time at 37 °C (if necessary, additional ...
-
>Listeria Monocytogenes
-
ลำดับในการตรวจหาเชื้อซาลโมเนลลา 48 ชั่วโมง 1 เตรียมตัวอย่าง (25 กรัม เติมใส่ลงใน BPW 225 mL) 2 พรี-เอนริช(24 h incubation time at 37 °C ) 3 หยอดสารบนตลับเพลทตรวจเชื้อซาลโมเนลลา (...
-
Compact Dry VPตลับเพลทตรวจนับเชื้อตรวจหาเชื้อวิบริโอ พาราเฮโมไลติคัส ขั้นตอนทดสอบ - บ่มเพลท Incubation Temperature 35±2℃ - ใช้เวลา Incubation Time 24±2 hours (ชั่วโมง) - การอ่านแปล...
-
ตลับเพลทพร้อมใช้ ตรวจหาเชื้อลิสทีเรีย โมโนไซโตจีเนส (Listeria Monocytogenes) แบบพร้อมใช้งาน เหมาะสำหรับ ใช้ทดสอบหาเชื้อในผลิตภัณฑ์อาหารสดReady To Eat Food อาหารสำเร็จรูปพร้อมรับประ...
-
Compact Dry AQ ตลับตรวจจำนวนเชื้อ heterotrophic bacteria แบคทีเรียเฮเทอโรโทรฟิก ควรทดสอบในน้ำบรรจุขวดปิดสนิท Compact Dry ETB ตลับตรวจจำนวนเชื้อเอนเทอโรแบคทีริเชียอิ (Enterobacteri...
-
เหมาะสำหรับ งานวิจัย R&D เครื่องตรวจปริมาณจำนวนเชื้อจุลชีพ อย่างเร่งด่วน* โดยหลักการวัดการเรืองแสงฟลูออเรสเซนต์ Fluorescent assay (ไม่ต้องการใช้เครื่องอุ่นสาร) วิธีการทดสอบ Me...
-
environmental surface swab,dilution rack,small incubator,incubox (thermocult),whirl-pak bags,disposables,steri-ware,sterilizing solution ( disinfectants ),etc.